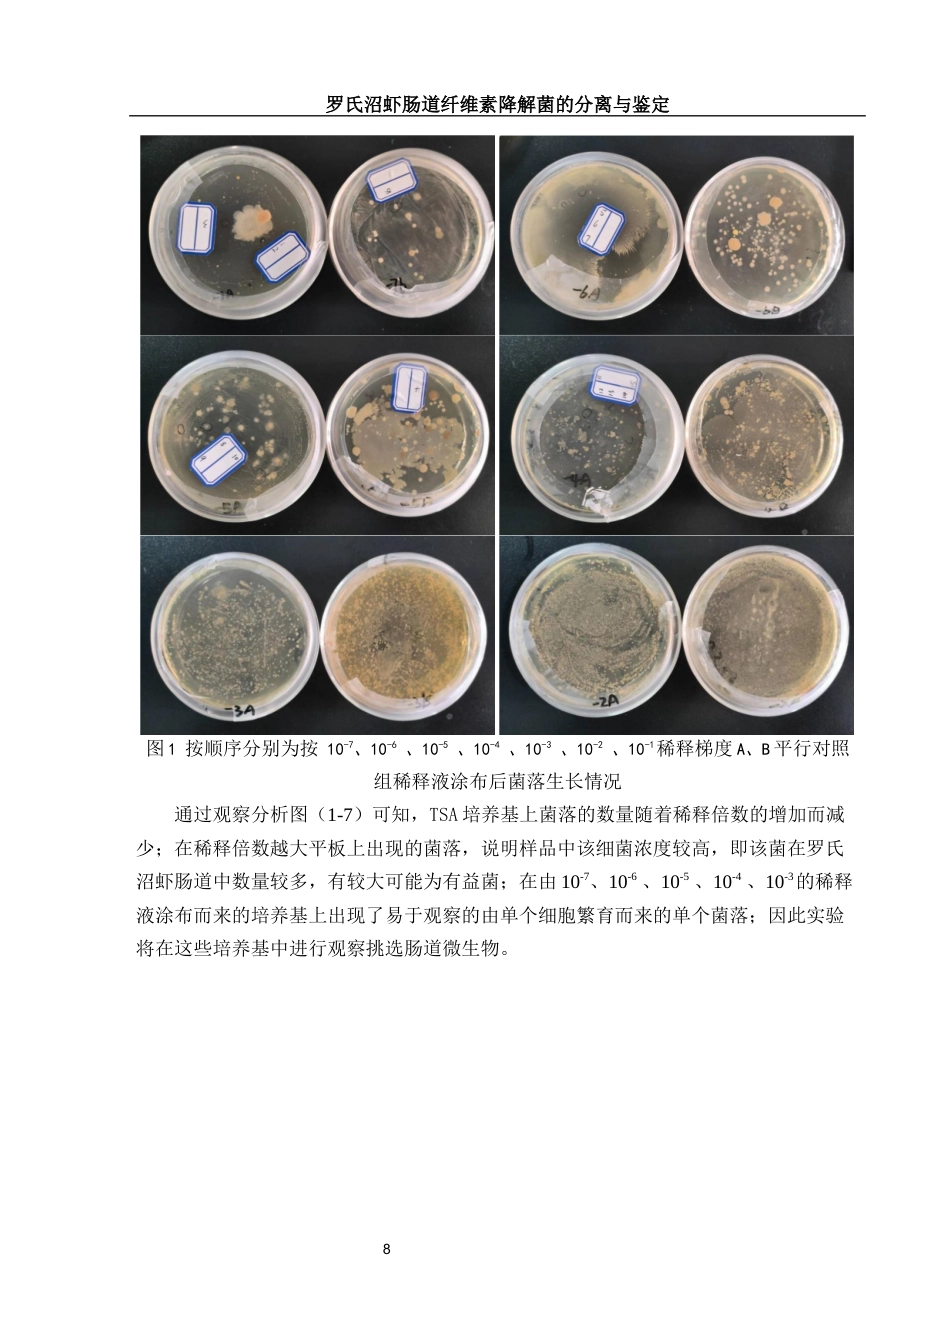
25年WH动物科学 罗氏沼虾肠道纤维素降解菌的分离与鉴定18.51-AI0.55终稿-约21200字符.docx_第9页
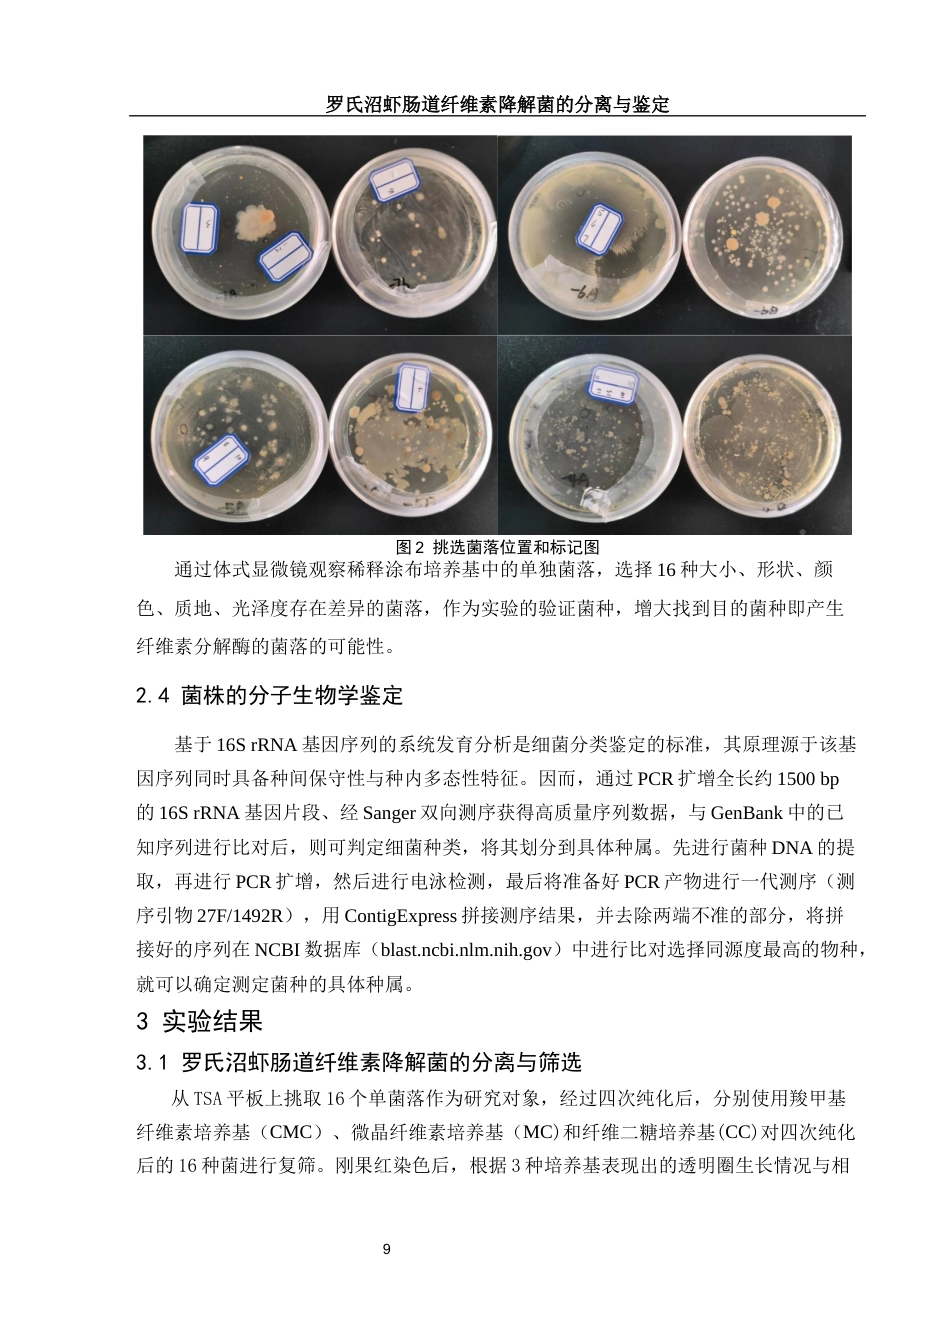
25年WH动物科学 罗氏沼虾肠道纤维素降解菌的分离与鉴定18.51-AI0.55终稿-约21200字符.docx_第10页

目 录摘要......................................................................1Abstract..................................................................21 前言....................................................................31.1 罗氏沼虾概述.......................................................31.2 肠道微生物相关研究动态.............................................31.2.1 肠道微生物的研究方法..........................................31.2.2 罗氏沼虾肠道微生物的相关研究..................................41.3 纤维素...

发表评论取消回复